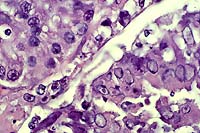

Results
AFIP Wednesday Slide Conference - No. 4
23 September 1998
- Conference Moderator:
MAJ Dana P. Scott, Diplomate, ACVP
Department of Veterinary Pathology
Armed Forces Institute of Pathology
Washington, DC 20307
-
- NOTE: Click on images for larger views. Use
browser's "Back" button to return to this page.
Return to WSC Case Menu
-
- Case I - 351-97 (AFIP 2639852)
-
- Signalment: Juvenile striped skunk (Mephitis mephitis),
female, 3 and 1/2 months old.
-
- History: Part of a group of juvenile striped skunks
that were hand raised from birth by private individuals. These
skunks (N=10) were kept in quarantine for 24 days before this
skunk (351-97) died. No clinical signs were observed the day
before this animal's death. Blood was drawn for CBC and biochemistry
the day prior to death.
-
- Gross Pathology: Gross lesions included diffuse, mild
icterus in the subcutis and omental adipose tissue, and petechiae
and ecchymoses throughout the subcutis. There was approximately
1 ml of clear yellow fluid in the abdominal cavity. The liver
was markedly enlarged and diffusely mottled yellow, with an enlarged
and edematous gall bladder. Other gross findings included mild
bilateral renal enlargement and marked splenomegaly.
-
- Laboratory Results: Blood work revealed a low WBC
count (1595). The differential count was segmented neutrophils
(32%), lymphocytes (64%), and eosinophils (4%). Biochemistry
results demonstrated a very high AST (470 IU/L), ALT (332 IU/L),
total bilirubin (1.2 mg/dl), and LDH (1722 IU/L). There was slightly
decreased total protein (4.7 gm/dl) and hypoalbuminemia (2.0
gm/dl).
-
- Contributor's Diagnosis and Comments:
- 1. Liver: Hepatitis, subacute, diffuse, severe, with intranuclear
inclusion bodies and multifocal, minimal random necrosis and
hemorrhage, consistent with infectious canine hepatitis (canine
adenovirus Type 1).
- 2. Spleen: Congestion, diffuse, severe with intraphagocytic
hemosiderosis and few intraendothelial intranuclear amphophilic
to basophilic inclusion bodies, compatible with canine adenovirus
Type 1.
-
- Viral isolation, histologic features, and electron microscopy
confirm a diagnosis of infectious canine hepatitis (ICH) in this
striped skunk. Infectious canine hepatitis (canine adenovirus
type I) causes disease worldwide in many canidae, including domestic
dogs, foxes, skunks, wolves, and coyote (Cabasso 1981, Appel
1987). Karstad et al. (1975) document infectious canine hepatitis
causing acute, fatal hepatitis in striped skunks, and suggest
that striped skunks may be a natural wildlife host of infectious
canine hepatitis.
-
- Infectious canine hepatitis is spread by direct contact,
and the host becomes infected by ingestion of viral particles
in urine, feces, or saliva of infected animals. Infected urine
is the most important source for transmission, and the virus
may be shed in the urine for at least 6 months after infection
(Appel 1987). Infected animals may die acutely without clinical
signs or may have abdominal pain, vomiting, diarrhea, petechial
and ecchymotic hemorrhages, and icterus (Appel 1987).
-
- Skunks and foxes with ICH often die acutely with no clinical
signs (Cabasso 1981). Canine adenovirus type I has an affinity
for hepatocytes, endothelial cells, and Kupffer cells, accounting
for the hemorrhage (due to vascular endothelial damage) and icterus
(hepatocyte damage) present grossly in many cases (Jones and
Hunt 1997).
-
- Animals that recover from infection or that have been vaccinated
with a live attenuated adenovirus vaccine may have a transient
immune complex uveitis, iridocyclitis, and corneal edema ("blue
eye") (Tizard 1996). Dogs that recover from infection are
immune to ICH for life (Appel 1987).
 40x
Obj.
40x
Obj.
- Case 4-1. Liver. Large portal vein to right contains
sloughing cells with basophilic intranuclear inclusions. Similar
intranuclear inclusions are in most degenerating hepatocytes
as well.
-
- AFIP Diagnosis: Liver: Hepatocellular degeneration
and necrosis, diffuse, with mild multifocal acute hepatitis and
vasculitis, numerous hepatocellular intranuclear inclusion bodies,
and rare endothelial intranuclear inclusion bodies, striped skunk
(Mephitis mephitis), mustelid.
-
- Conference Note: Canine adenovirus type-1 (CAV-1)
has worldwide serologic homogeneity and shares many immunologic
similarities to human adenoviruses, but is antigenically and
genetically distinct from CAV-2, a cause of respiratory disease
in the dog. In immunohistochemical studies performed at the AFIP,
positive staining of intranuclear inclusion bodies was observed
in hepatocytes, Kupffer cells, and endothelial cells utilizing
antibodies to human adenovirus.
-
- After gaining entry through the oronasal cavity, the virus
localizes in the tonsils and then spreads to other lymphoid organs.
In rare instances, severe tonsillitis is associated with edema
of the larynx or pharynx that can be fatal. The virus reaches
the blood via the thoracic duct and viremia ensues, lasting four
to eight days post infection. The virus becomes disseminated
to other tissues and body fluids, including saliva, urine, and
feces. During this phase, the virus localizes and damages hepatocytes
and endothelial cells. The cytotoxic effects of the virus cause
the initial cellular injuries in the liver, kidney, and eye.
In dogs, the hepatic necrosis which occurs during this stage
of infection may be self-limiting and restricted to centrilobular
areas. The reticulin framework of the liver remains intact, and
hepatic regeneration quickly follows with little evidence of
clinical disease. In cases with overt clinical signs, either
recovery or death occurs after several days of anorexia, apathy,
vomiting, diarrhea, and abdominal pain.
-
- Because the virus is endotheliotrophic, widespread intimal
damage exposes the underlying subendothelial collagen initiating
diffuse activation of the clotting cascade with resultant consumption
of clotting factors and platelets. A hemorrhagic diathesis results,
and petechiae, ecchymoses, epistaxis and prolonged hemorrhage
from venipuncture sites may be observed clinically. Bleeding
into the brain occurs in a small percentage of cases, and some
sudden deaths in dogs may be caused by acute midbrain hemorrhage.
- In rare instances, a peracute form of the disease occurs,
and these severely affected dogs become moribund and die with
few, if any, clinical signs during initial viremia. The animal
is found dead, and owners often suspect poisoning as the cause.
This form of the disease in the dog is reminiscent of the clinical
history described for this skunk.
-
- Contributor: Wildlife Conservation Society, Department
of Pathology, 185th St. and Southern Blvd., Bronx, NY 10460.
-
- References:
- 1. Appel M: Canine adenovirus type I (infectious canine hepatitis).
In: Virus Infections of Carnivores, pp. 29-44, Elsevier Science
Publishers, New York, 1987.
- 2. Cabasso V: Infectious canine hepatitis. In: Infectious
Diseases of Wild Animals, Davis, Karstad, Trainer eds., pp. 191-195,
Iowa State University Press, Ames, Iowa, 1981.
- 3. Jones TC, Hunt RD, King NW: Diseases caused by viruses.
In: Veterinary Pathology, 6th ed., pp. 241-245, Williams and
Wilkins, Philadelphia, 1997.
- 4. Karstad LR, Ramsden R, Berry TJ, Binn LN: Hepatitis in
skunks caused by the virus of infectious canine hepatitis. J
Wild Dis 11:494-496, 1975.
- 5. Tizard I: Immune complexes and type III hypersensitivity.
In: Veterinary Immunology: An Introduction, 5th ed., pp.368-371,
WB Saunders Company, Philadelphia, 1996.
- 6. Greene CE: Infectious canine hepatitis. In: Infectious
Diseases of the Dog and Cat, 2nd ed., pp. 22-27, WB Saunders
Co., Philadelphia, 1998.
-
- International Veterinary Pathology Slide Bank:
Laser disc frame #'s 17187-89; 16883.
-
- Case II - 8004-98 (AFIP 2640591)
Signalment: Canine, male, neutered, German Shepherd Dog,
six-year-old.
History: One week prior to euthanasia, this dog was examined
by a referring veterinarian for lethargy. Two days later, anterior
uveitis (OD) and posterior paresis were evident.
-
- Gross Pathology: Throughout the right kidney, but
particularly in the medulla, were small yellow-white foci. The
body of T13 was friable, yellow-tan, and dorsally displaced.
The T13/ L1 disk was absent. The body of L1 was rough and red.
-
- Laboratory Results: Spinal radiographs revealed collapse
of the T13/L1 intervertebral disk space with lysis and periosteal
bone proliferation of the T13 and L1 vertebral bodies. A myelogram
revealed compression of the spinal cord in this area. Cytology
of a fine-needle aspirate of the affected disk revealed fungal
hyphae and spores. Aspergillus terreus was isolated.
-
- Contributor's Diagnosis and Comments: Kidney: Tubular-interstitial
nephritis, pyogranulomatous, with thromboangiitis, hemorrhage,
and numerous fungal elements (septate hyphae and spores).
-
- This case is an example of disseminated Aspergillus terreus
infection in a dog. German Shepherd Dogs are probably predisposed
to infection with this saprophytic fungus. In the kidney, the
medulla is usually affected more than the cortex. Vertebrae are
common sites of fungal localization. The pathogenesis obviously
involves hematogenous dissemination (mycethemia). In section,
Aspergillus terreus spores that branch laterally from septate
hyphae are termed aleuriospores.
 40x
Obj.
40x
Obj.
- Case 4-2. Kidney. There is multifocal liquefactive
necrosis of medullary collecting tubules characterized by an
infiltrate of neutrophils, histiocytes, and occasional faint
5-10µ yeasts.
 40x
Obj.
40x
Obj.
- Case 4-2. Kidney. Lumena of necrotic collecting tubules
are filled with pale fungal hyphae and surrounded by neutrophils
and fewer macrophages.
-
- AFIP Diagnosis: Kidney: Nephritis, necrosuppurative,
multifocally extensive, severe, with necrotizing vasculitis and
numerous fungal hyphae, German Shepherd Dog, canine, etiology
consistent with Aspergillus sp.
-
- Conference Note: Aspergillus sp., common saprophytic
molds, are not usually pathogens, but cause opportunistic infections.
Aspergillosis is most common and severe in poultry, especially
chicks and turkey poults, where infection is due to contaminated
bedding and may occur as an epizootic with high mortality.
In people and cats, disseminated aspergillosis occurs most frequently
in hosts that are debilitated or immunosuppressed by a variety
of underlying conditions such as neoplasia (malignant lymphoma),
infectious agents (panleukopenia, FeLV, AIDS), and drug therapy
(glucocorticoids, prolonged antibiotic use). Disseminated canine
aspergillosis is a rare disease most often caused by Aspergillus
terreus. It occurs most commonly in German Shepherd Dogs. Predisposing
factors leading to disseminated aspergillosis in dogs may include
optimal environmental conditions for growth of the organism,
infection with particularly virulent fungal strains, and a genetically
based immunodeficiency, such as a defect in mucosal immunity
or defects in phagocyte or neutrophil function. Unlike disseminated
aspergillosis, nasal aspergillosis in the dog is most commonly
caused by A. fumigatus.
-
- The exact portal of entry for A. terreus is unknown, but
fungal conidia or aleuriospores may enter the host and establish
initial infection through the respiratory or gastrointestinal
tract. In man, infection follows inhalation of spores, and organisms
proliferate within previously diseased areas of the lung, such
as resolved tuberculosis lesions. Alternatively, some infections
may be initiated by surgery or intravenous inoculation. Once
entry is gained and infection is established, the ability of
the organism to invade and disrupt vessels allows hematogenous
spread via circulating aleuriospores. In section, aleuriospores
are lateral branching spherical vesicles occasionally found along
thin-walled fungal hyphae of A. terreus. The GMS method demonstrated
numerous aleuriospores in this case. These distinctive structures
allow specific histopathologic diagnosis of A. terreus infection.
-
- The distribution of gross lesions in this dog is similar
to the findings reported in a retrospective study of ten dogs
with disseminated aspergillosis. Lesions in these dogs frequently
developed in the kidneys, spleen, long bones, and the epiphyses
of vertebra and sternebra. Terminal capillary loops and slow
blood flow characterize these anatomical locations. The renal
medulla has numerous arteriolae rectae which terminate in capillary
loops, and may explain the predominate medullary distribution
of lesions in this dog. The organism's ability to invade and
disrupt vessels leads to activation of the coagulation cascade,
thrombosis, and infarction. Vascular stasis and thrombosis are
important in the development of osteomyelitis.
Conference participants discussed Fusarium sp. as another cause
of fungal nephritis. Fusarium is an environmental saprophyte
which may be found as a part of the normal microflora of the
canine skin. The organism has been reported as an infrequent
cause of mycotic disease in dogs, including cases of ascending
unilateral pyelonephritis in a Newfoundland and disseminated
disease in a German Shepherd. The organism in the Newfoundland
occurred as dense mycelial mats of branching septate fungal hyphae
with occasional terminal globose heads; aleuriospores were not
described. Immunohistochemistry confirmed the identity of the
organism.
Contributor: Animal Disease Diagnostic Laboratory, ADDL-1175,
Purdue University, West Lafayette, IN 47907.
-
- References:
- 1. Kabay MJ, Robinson WF, Huxtable CRR, McAleer R: The pathology
of disseminated Aspergillus terreus infection in dogs. Vet Pathol
22:540-547, 1985.
- 2. Day MJ, Holt PE: Unilateral fungal pyelonephritis in a
dog. Vet Pathol 31:250-252, 1994.
- 3. Jones TC, Hunt RD, King NW: Diseases caused by fungi.
In: Veterinary Pathology, 6th ed., pp. 506-507, Williams and
Wilkins, 1997.
- 4. Day MJ: Canine disseminated aspergillosis. In: Infectious
Diseases of the Dog and Cat, 2nd ed., pp. 409-412, WB Saunders
Co., Philadelphia, 1998.
- 5. Cotran RS, Kumar V, Robbins SL: Infectious diseases. In:
Robbins Pathologic Basis of Disease, 5th ed., pp. 355-356, WB
Saunders Co., 1994.
-
- Case III - Fac. Med. Vet. da USP 2 (AFIP 2641266)
-
- Signalment: Adult, male, howler monkey, Alouatta fusca,
Cebidae, New World non-human primate.
-
- History: This free-ranging howler monkey was kept
in captivity for six months due to an ongoing reintroduction
program. During this period, the animal was identified with a
microchip and submitted to multiple serological assays, including
rabies, leptospirosis, malaria and Lyme disease, and periodical
clinical examination. After this period, the monkey was released
in a remaining tropical rain forest close to São Paulo
City. Ten days after reintroduction to the wild, it was found
in an agonal state due to a dog attack.
-
- Gross Pathology: Grossly, the howler monkey presented
with extensive multifocal hemorrhages associated with dog bites.
Within the oral cavity, there were multiple, two to five millimeter
diameter, soft, white, isolated to coalescing masses which affected
the mucosa of the lower lip and the craniomedial aspect of the
tongue. Other major findings were pulmonary edema, typhlitis
due to Enterobius sp., and multifocal ulcerative colitis.
-
- Laboratory Results:
- 1. Heart blood cultures: Negative.
2. Liver cultures: Negative.
3. Serological essays for rabies, malaria, Lyme disease, leptospirosis:
Negative.
4. Immunohistochemistry assays for papillomavirus (polyclonal
antibody-DAKO ä, dilution 1:8000): Positive.
5. Immunohistochemistry assays for human papillomavirus types
6, 11, 18 (monoclonal antibody NOVOCASTRAä, dilution 1:40):
Negative.
6. In situ hybridization for detection of DNA of human papillomavirus
types 6, 11, 16, 18, 30, 31, 33, 35, 45, 51 and 52 (DAKOä):
Negative.
-
- Contributor's Diagnosis and Comments: Mucosa, lower
lip: Acanthosis, moderate, associated with marked koilocytosis,
fusion of rete ridges, and minimal hyperparakeratosis (Focal
Epithelial Hyperplasia, FEH - Heck's Disease) due to papillomavirus,
howler monkey (Alouatta fusca), Cebidae, New World non-human
primate.
-
- Focal Epithelial Hyperplasia (FEH), also known as Heck's
disease, is an uncommon condition, occurring only in the oral
cavity, and related to papillomavirus infection. It has been
described in humans (South, Central, and North American Indians
and Eskimos), chimpanzees (Pan troglodytes), pygmy chimpanzees
(Pan paniscus) and the domestic rabbit. FEH has never been reported
in New World Primates.
Grossly, FEH is defined as well-circumscribed or coalescing,
slightly elevated, soft masses or papules, 0.1 to 0.5 cm in diameter,
affecting mainly the lower lip and buccal mucosa. Lesions are
usually white to pink. Microscopically, FEH is mainly characterized
by mild to severe focal acanthosis associated with elongation
and fusion of the rete ridges and keratinocyte vacuolization
(koilocytosis).
In humans, in situ DNA hybridization exams revealed that human
papillomavirus types 13 and 32 are markedly specific for FEH.
In non-human primates, molecular biology assays were performed
in the pygmy chimpanzee, revealing the presence of an agent related
to HPV-13, tentatively named pygmy chimpanzee papillomavirus.
In the present case, the gross and microscopic features are in
accordance with those described in the literature for FEH. The
nature of the viral antigen was determined using a rabbit polyclonal
antibody to bovine papillomavirus. Subsequent immunohistochemistry
assays for HPV and in situ HPV DNA hybridization exams were negative,
suggesting the possibility that the agent is not related to the
known papillomaviruses. Further studies are planned to clarify
this possibility.
 40x
Obj.
40x
Obj.
- Case 4-3. Lip. There is proliferation and ballooning
degeneration of the acanthocytes. Within the clear cytoplasm
are numerous minute, granular inclusions. (The surface is to
the right).
-
- AFIP Diagnosis: Oral mucosa, epithelium: Hyperplasia,
diffuse, severe, with numerous koilocytes, vacuolar degeneration,
and few intranuclear inclusions, howler monkey (Alouatta fusca),
nonhuman primate.
-
- Conference Note: Papillomaviruses are a large, heterogenous
group of small, double-stranded DNA viruses noted for their ability
to induce epithelial proliferation. Papillomaviruses are usually
species and target cell specific.
-
- The term multifocal papilloma virus epithelial hyperplasia
(MPVEH) has been suggested as a more appropriate name for FEH
because it describes the nature and pathology of the disease.
Microscopically, the lesions are characterized by acanthosis
of the mucosal epithelium, anastomosing rete ridges which often
point radially toward the center of the lesion, parakeratotic
hyperkeratosis, and vacuolar degeneration of keratinocytes. Within
the hyperplastic basal layers of the epithelium, a few keratinocytes
may be swollen with abundant clear cytoplasm and contain an irregularly
enlarged nucleus with central amphophilic to basophilic granularity.
The nuclear changes are highly diagnostic for MPVEH in humans.
In this howler monkey, rare basal epithelial cells demonstrate
similar histologic changes. The term "mitosoid" has
previously been applied to the nuclear changes in human lesions;
however, the term is confusing, may lead to erroneous interpretations,
and should be avoided.
-
- Explanations for the epidemiological distribution of human
disease noted by the contributor are varied, and several socioeconomic
and genetically based hypotheses have been proposed. Papillomaviruses
may demonstrate a viral site specificity for infection, and this
mechanism is proposed for MPVEH and HPV32. The site of viral
specificity is dependent on the numbers and distribution of cell
membrane receptors. Affected families or ethnic groups may have
higher numbers of these cell receptors and thus a greater likelihood
of infection. It has also been observed that MPVEH often affects
individuals in lower income groups, suggesting that malnutrition,
chronic immunodeficiency, and poor hygiene may correlate with
risk of infection and disease transmission.
-
- Several DNA and RNA viruses are known to be oncogenic in
humans and animals. Human papillomaviruses are involved in the
genesis of a variety of epithelial tumors in man, including benign
squamous papillomas as well as squamous cell carcinoma of the
cervix and anogenital region. The oncogenic properties of papillomaviruses
are related to products of two early papillomaviral genes, E6
and E7.
-
- The E7 viral protein binds to the cellular tumor suppressor
gene retinoblastoma protein (Rb). This affects the ability of
the Rb gene product (pRb) to bind and sequester cellular transcription
factors involved in the initiation of DNA synthesis. With these
transcription factors liberated from pRb, the molecular controls
on the cell cycle are released, DNA synthesis is triggered, and
the normally quiescent cells quickly reenter the cell cycle resulting
in indiscriminate proliferation.
-
- The E6 protein binds to and inactivates p21, the product
of the cellular tumor suppressor gene p53. Normally, when cellular
DNA is damaged, as occurs in viral infections or due to mutagenic
chemicals, p53 accumulates in the nucleus and acts by inducing
the transcription of p21. When functional, p21 protein is a potent
inhibitor of the cyclin-dependent kinase system (it inhibits
the formation of cyclin/CDK complexes) and blocks the phosphorylation
pRb. The pRb protein remains in the active, unphosphorylated
state, thus preventing the cell from entering the S phase of
the cell cycle. This pause in the cell cycle allows for repair
of damaged cellular DNA. With inactivation of p21 protein, cells
with damaged DNA are allowed to reenter the cell cycle and proliferate
without proper repair, thus leading to potential oncogenesis.
-
- Both the p53 gene and Rb gene act in the nucleus and work
by inhibiting the cell cycle. Unlike the Rb gene, however, p53
does not continually police the normal cell, but is activated
during periods of damage to cellular DNA. Should the DNA repair
mechanisms fail, the p53 gene stops the cell from dividing and
activates the cell-suicide genes in the process known as apoptosis.
Apparently, papillomaviruses may act to prevent this fail safe
mechanism of p53, and uncontrolled, sometimes malignant proliferation
of virally infected cells occurs.
-
- Contributor: University of São Paulo, Faculty
of Veterinary Medicine and Zootechny, Department of Pathology,
Av. Prof. Orlando Marques de Paiva 87, Cidade Universitária,
São Paulo SP 05508-900, Brazil.
References:
- 1. Anderson DC, McClure HM: Focal epithelial hyperplasia,
chimpanzees. In: Monographs on Pathology of Laboratory Animals:
Nonhuman Primates, Jones, Mohr, Hunt eds., pp. 233-237, Springer-Verlag,
New York, 1993.
- 2. Viraben R, et al.: Focal Epithelial Hyperplasia (Heck
disease) associated with AIDS. Dermatology 193:261-262, 1996.
- 3. Van Ranst M, et al.: A papillomavirus related to HPV type
13 in oral focal epithelial hyperplasia in the pygmy chimpanzee.
J Oral Pathol Med 20:325-321, 1991.
- 4. Roman CB, Sedano HO: Multifocal papilloma virus epithelial
hyperplasia. J Oral Surg Oral Med Oral Path 77:631-635, 1994.
- 5. Kumar V, Cotran RS, Robbins SL: Neoplasia. In: Basic Pathology,
6th ed., pp.153-167, WB Saunders Co., Philadelphia, 1997.
-
- Case IV - 568-94 (AFIP 2639850)
- Signalment: Nine-year-old, adult, female leopard cat
(Felis bengalensis).
- 2 histology images (previously improperly labeled 4-1)


-
- History: This animal had no history of current medical
problems. The keeper reported she had eaten her dinner normally
the night before. The following morning, she exhibited respiratory
distress. With handling, the dyspnea progressed to respiratory
arrest, and the cat died shortly after intubation.
Gross Pathology: The lungs were firm and mottled, and
the right anteroventral lobe was plum colored. The trachea contained
moderate amounts of blood-tinged foam. There were no other gross
lesions. A lung swab was submitted for bacterial culture. Tissues
were frozen at minus 70o C.
-
- Laboratory Results: Viral isolation of the lung tissue
was positive for feline herpesvirus. Aerobic bacterial cultures
of the lung had no growth. Immunoperoxidase staining for toxoplasmosis
was negative.
-
- Contributor's Diagnosis and Comments: 1. Bronchi and
bronchioles: Bronchitis and bronchiolitis, subacute, necrotizing,
multifocally extensive, moderate to severe, with extension into
alveolar tissue, and intraepithelial intranuclear inclusion bodies
(feline herpesvirus Type I). 2. Alveolar edema and emphysema,
multifocally extensive, moderate to severe. 3. Peribronchiolar
glands: Hyperplasia, moderate.
-
- Feline viral rhinotracheitis (FVR) is an infection of all
Felidae and is caused by feline herpesvirus type I (FHV-1), a
member of the Alphaherpesvirinae subfamily of Herpesviridae.1,3,6
The first documented isolation of the FVR virus in an exotic
felid was reported at the St. Louis Zoo in 1977 where it caused
the deaths of three out of five clouded leopards (Felis nebulosa)
in a single outbreak.
-
- In domestic cats, infection with FHV-1 accounts for 40 to
50% of all upper respiratory diseases.1 The virus has a predilection
for the epithelium of nasal passages, pharynx, soft palate, conjunctivae,
tonsils, and, to a lesser extent, trachea.4 Clinical signs correspond
to these sites of viral replication and consist of paroxysmal
sneezing, coughing, salivation, fever, and serous to mucopurulent
nasal and conjunctival discharges.4 Although morbidity is quite
high, most cats recover within two weeks with supportive care.
Many of these cats become asymptomatic carriers and may shed
virus at later times of stress.
- This leopard cat had an unusual presentation. No lesions
were found in the nasal passages, oral cavity, tonsils, or conjunctivae.
Histologic lesions were limited to the lower respiratory tract
and centered on the bronchi and bronchioles with extension into
the adjacent alveolar tissue. As viral inclusions were not identified
in the initial sections, other causes of feline respiratory disease
were considered including feline calicivirus, feline reovirus,
the feline-adapted strain of Chlamydia psittaci (feline pneumonitis
agent), Mycoplasma felis, Bordetella bronchiseptica and Pasteurella
multocida. However, bacterial cultures and Giemsa stains for
Chlamydia were negative. Immunoperoxidase staining for toxoplasmosis
was also negative. Additional recuts of lung tissue revealed
smudgy to clearly distinct intranuclear inclusion bodies in sloughed
bronchiolar epithelial cells. Tissue was submitted for viral
isolation and was positive for feline herpesvirus.
-
- As was the case in the St. Louis outbreak, there was no identifiable
source of exposure of the cats to the virus. No management changes
(i.e., shipment, handling, change of enclosures) had occurred
for an extended period of time before the disease onset. The
most likely explanation in these cases is that there was a recrudescence
of a latent infection. Although in domestic cats subsequent infections
are usually less severe than the initial infection, this may
not be true of exotic felids. Many zoos now vaccinate on a six
month basis due to the high mortality rate.
 40x
Obj.
40x
Obj.
- Case 4-4. Lung. There is proliferation of type II
pneumocytes. Alveoli are filled with macrophages, fewer lymphocytes
and edema and occasionally contain syncytia. Alveolar septae
are thickened by fibrin, histiocytes and large pneumocytes.
-
- AFIP Diagnosis: Lung: Pneumonia, bronchointerstitial,
necrotizing, acute to subacute, diffuse, with alveolar edema,
few syncytial cells, and numerous amphophilic and eosinophilic
intranuclear inclusions, leopard cat (Felis bengalensis), feline.
-
- Conference Note: Herpesviruses infect a wide variety
of animals from insects through vertebrates, and with the possible
exception of sheep, a herpesvirus is the cause of at least one
major disease in each of the domestic species. Herpesviruses
are classically divided into three subfamilies: a-herpesvirinae,
b-herpesvirinae, and g-herpesvirinae. Generally, the a-herpesvirinae
are rapidly growing, cytolytic viruses that have the ability
to establish latent infections in nerve ganglia (especially the
trigeminal), and may have a broad host range. Examples are numerous
but include infectious bovine rhinotracheitis, coital exanthema
of equids, duck plague, and pseudorabies. The cytomegaloviruses,
or b-herpesvirinae, have a restricted host range, slow viral
replication which does not cause cell lysis until several days
after infection, and may remain latent in secretory glands, lymphoreticular
tissue, kidneys, and other tissues. A few examples include equine
cytomegalovirus infection (EHV-2) and inclusion body rhinitis
of swine (porcine herpesvirus-2). The final group, the g-herpesvirinae,
are known for their predilection to infect and remain latent
within lymphoid cells, though they may cause cytocidal infections
in epithelial and fibroblastic cells. Classic examples include
Epstein-Barr virus in man and malignant catarrhal fever of bovids
(Alcelaphine herpesvirus 1).
-
- Feline rhinotracheitis virus (FRV) is a typical a-herpesvirus
that measures between 120-200nm (average 150nm), contains double-stranded
DNA, replicates in the cell nucleus, and becomes enveloped by
budding through invaginations of the nuclear membrane. Infection
with FVR is naturally acquired through oral, nasal or conjunctival
routes by either direct contact or from aerosolized oronasal
secretions of virus-shedding infected cats. After an incubation
of 24-48 hours, the onset of typical clinical signs of an upper
respiratory tract infection occurs, accompanied by profuse salivation
and corneal ulcers. While oral ulceration may also be present
in FVR, this lesion is more typical of feline calicivirus infections.
-
- Viral replication occurs primarily in the epithelium of nasal
cavity, nasopharynx, turbinates, and in the tonsils. Shedding
of viral particles may begin as early as 24 hours post infection
and may last as long as one to three weeks, though most active
viral replication and cell necrosis occur between two to seven
days post infection. During this period, the herpesviral intranuclear
inclusions are most often present in infected epithelial cells
and occasionally within endothelial cells. Because viral replication
is normally restricted to areas of lower body temperature, such
as the upper respiratory passages, viremia is rare, and resolution
of disease normally takes between two to three weeks.
-
- Uncommonly, generalized disease may follow initial upper
respiratory tract infection in debilitated or immunocompromised
animals and in neonatal kittens. In these cases viremia may be
present. Mortality due to FVR is rare in domestic cats, but when
fulminating cases of viral infection occur, there is often widespread
necrotizing bronchitis, bronchiolitis, and interstitial pneumonia
with edema. Viral infection may predispose to fatal secondary
bacterial bronchopneumonia.
-
- Contributor: Wildlife Conservation Society, Department
of Pathology, 185th St. and Southern Blvd., Bronx, NY 10460
-
- References:
- 1. Baldwin CA: Feline Viral Rhinotracheitis. In: Veterinary
Diagnostic Virology, Castro, Heuschele eds., pp. 189-191, Mosby
Year Book, St. Louis, 1992.
- 2. Boever WK, McDonald S, Solorzand RF: Feline viral rhinotracheitis
in a colony of clouded leopards. Veterinary Medicine/Small Animal
Clinician Exotic Species. December 1977:1859-1866.
- 3. Fowler ME: Carnivores. In: Zoo and Wild Animal Medicine,
2nd ed. , pp.834-836, 1986.
- 4. Jubb KVF, Kennedy PC, Palmer N: The respiratory system.
In: Pathology of Domestic Animals, 4th ed., vol. 2, pp. 558-559,
Academic Press, 1993.
- 5. Pedersen NC: Feline herpesvirus type I (feline rhinotracheitis
virus). In: Virus Infections of Carnivores, Appel ed., Vol. 1,
pp. 227-237, Elsevier Science Publishers, 1987.
- 6. Wallach JD, Boever WJ: Diseases of Exotic Animals. In:
Medical and Surgical Management, pp. 368-369, WB Saunders Company,
Philadelphia, 1983.
- 7. Gaskell R, Dawson S: Feline respiratory disease. In: Infectious
Diseases of the Dog and Cat, 2nd ed., pp. 97-106, WB Saunders
Co., Philadelphia, 1998.
- 8. Fenner FJ, et al.: Herpesviridae. In: Veterinary Virology,
2nd ed., pp. 337-368, Academic Press Inc., San Diego, 1993
-
- International Veterinary Pathology Slide Bank:
Laser disc frame #'s 4877 and 15417.
-
- Ed Stevens, DVM
Captain, United States Army
Registry of Veterinary Pathology*
Department of Veterinary Pathology
Armed Forces Institute of Pathology
(202)782-2615; DSN: 662-2615
Internet: STEVENSE@afip.osd.mil
-
- * The American Veterinary Medical Association and the American
College of Veterinary Pathologists are co-sponsors of the Registry
of Veterinary Pathology. The C.L. Davis Foundation also provides
substantial support for the Registry.
Return to WSC Case Menu
 40x
Obj.
40x
Obj.
 40x
Obj.
40x
Obj.
 40x
Obj.
40x
Obj.
 40x
Obj.
40x
Obj.

40x
Obj.
40x
Obj.